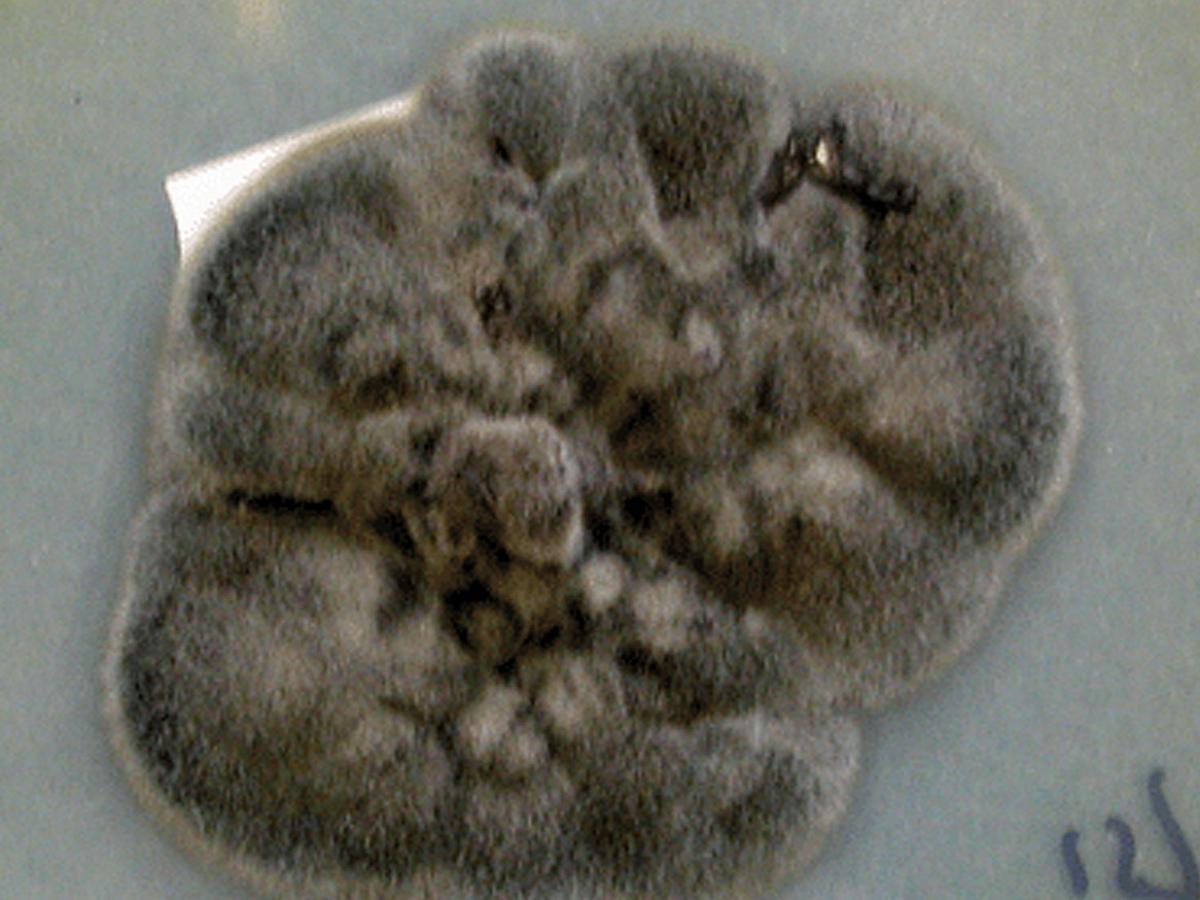
Culture

Unknown 45
Mould identification: a virtual self assessment
Case history
A 25-year-old male renal transplant recipient presented with a dark coloured subcutaneous nodule on his leg, which later became ulcerated. The culture shown below was isolated.
Culture

Microscopy

Microscopy